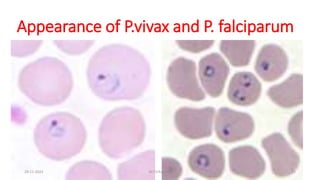
Appearance of P.vivax and P. falciparum
29-11-2023 Dr.T.V.Rao MD 21

Embed presentation
Download to read offline




















































































The document discusses various parasitic infections that can affect the central nervous system. It covers how parasites can cross the blood-brain barrier and challenges in diagnosing neuroparasitic infections. Common methods include microscopy examination of blood or tissue samples, as well as newer techniques like PCR and antigen detection tests. Specific infections discussed in detail include malaria, toxoplasmosis, and infections caused by free-living amebae. The document emphasizes the importance of integrating clinical signs and laboratory diagnostic methods for accurate diagnosis of neuroparasitic diseases.